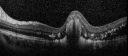
Fig__2_OCT_pre.jpg

Last additions - Congenital Anomalies
|

Coats' Disease - 14 year old - Asymptomatic501 viewsPresented with macular exudates. Temporal macroaneurysms responded to laser. Ultra-wide field FA shows nonperfusionNov 07, 2016
|
|

Coats' Disease - 14 year old - Asymptomatic477 viewsPresented with macular exudates. Temporal macroaneurysms responded to laser. Ultra-wide field FA shows nonperfusionNov 07, 2016
|
|

Coats' Disease - 14 year old - Asymptomatic478 viewsPresented with macular exudates. Temporal macroaneurysms responded to laser. Ultra-wide field FA shows nonperfusionNov 07, 2016
|
|

Coats' Disease - 14 year old - Asymptomatic482 viewsPresented with macular exudates. Temporal macroaneurysms responded to laser. Ultra-wide field FA shows nonperfusionNov 07, 2016
|
|

Coats' Disease - 14 year old - Asymptomatic527 viewsPresented with macular exudates. Temporal macroaneurysms responded to laser. Ultra-wide field FA shows nonperfusionNov 07, 2016
|
|

Coats' Disease - 14 year old - Asymptomatic507 viewsPresented with macular exudates. Temporal macroaneurysms responded to laser. Ultra-wide field FA shows nonperfusionNov 07, 2016
|
|

Coats' Disease - 14 year old - Asymptomatic481 viewsPresented with macular exudates. Temporal macroaneurysms responded to laser. Ultra-wide field FA shows nonperfusionNov 07, 2016
|
|

Coats' Disease - 14 year old - Asymptomatic655 viewsPresented with macular exudates. Temporal macroaneurysms responded to laser. Ultra-wide field FA shows nonperfusionNov 07, 2016
|
|

Sturge Weber SD OCT EDI showing choroidal thickening626 viewsMay 16, 2016
|
|

322 viewsOct 23, 2014
|
|

Coat's Disease425 views47 year old african-american male, presented under the assumption he had Sarcoidosis but appears more like Coat's DiseaseOct 23, 2014
|
|

Coat's Disease OD425 viewsOct 20, 2014
|
|

Hypertrophy of the Retinal Pigment Epithelium564 viewsPatient comes in with vision changes in the right eye. VA is 20/30 in the right eye. Fundus and FAF photos show a large area of Hypertrophy in the right eye.Sep 16, 2014
|
|

Hypertrophy of the Retinal Pigment Epithelium1354 viewsPatient comes in with vision changes in the right eye. VA is 20/30 in the right eye. Fundus and FAF photos show a large area of Hypertrophy in the right eye.Sep 16, 2014
|
|

Retinal Coloboma709 viewsYoung 19-year old female with Charge Syndrome comes in for eye exam. VA is 20/400, right eye, 20/30, left eye. Fundus photography shows coloboma covering the macula and pushing the optic nerve in the right eye. Jun 30, 2014
|
|

Retinal Coloboma936 viewsYoung 19-year old female with Charge Syndrome comes in for eye exam. VA is 20/400, right eye, 20/30, left eye. Fundus photography shows coloboma covering the macula and pushing the optic nerve in the right eye. Jun 30, 2014
|
|

589 viewsYoung 19-year old female with Charge Syndrome comes in for eye exam. VA is 20/400, right eye, 20/30, left eye. Fundus photography shows coloboma covering the macula and pushing the optic nerve in the right eye. Jun 30, 2014
|
|

697 viewsYoung 19-year old female with Charge Syndrome comes in for eye exam. VA is 20/400, right eye, 20/30, left eye. Fundus photography shows coloboma covering the macula and pushing the optic nerve in the right eye. Jun 30, 2014
|
|

Retinal Pigment Epithleium Dysgenesis - Autofluorescence558 viewsJun 06, 2014
|
|

Retinal Pigment Epithleium Dysgenesis - SD OCT line Scan477 viewsJun 06, 2014
|
|

Retinal Pigment Epithleium Dysgenesis - SD OCT line scan566 viewsJun 06, 2014
|
|

Retinal Pigment Epithleium Dysgenesis - Autofluorescence609 viewsJun 06, 2014
|
|

Retinal Pigment Epithleium Dysgenesis - Autofluorescence689 viewsJun 06, 2014
|
|

Retinal Pigment Epithleium Dysgenesis - Autofluorescence544 viewsJun 06, 2014
|
|

Retinal Pigment Epithleium Dysgenesis 622 viewsJun 06, 2014
|
|

Retinal Pigment Epithleium Dysgenesis 619 viewsJun 06, 2014
|
|

AVM522 viewsRF of AVM in OS of a 48 yr old female.Mar 11, 2014
|
|

AVM1053 viewsFP of AVM in OS of a 48 yr old female.Mar 11, 2014
|
|

AVM526 viewsFA of AVM in OS of a 48 yr old female.Mar 11, 2014
|
|

Choroidal Hemangioma - Diffuse - Enhanced Depth Imaging Spectral Domain OCT Line Scan - Abnormal Eye837 viewsChoroidal Thickness is 697 Microns from Diffuse Choroidal HemangiomaFeb 12, 2014
|
|

Choroidal Hemangioma - Diffuse - Enhanced Depth Imaging Spectral Domain OCT Line Scan - Abnormal Eye612 viewsChoroidal Thickness is 697 Microns from Diffuse Choroidal HemangiomaFeb 12, 2014
|
|

Choroidal Hemangioma - Diffuse - Enhanced Depth Imaging Spectral Domain OCT Line Scan - Normal Eye729 viewsNormal Choroidal Thickness in Right EyeFeb 12, 2014
|
|

Choroidal Hemangioma - Diffuse - Enhanced Depth Imaging Spectral Domain OCT Line Scan - Normal Eye620 viewsNormal Choroidal Thickness in Right EyeFeb 12, 2014
|
|

Coats' Disease with Cryotherapy 1244 viewsYoung male with Coat's Disease with Cryotherapy in the right eye. VA was 20/20, right eye. Left eye was completely normal. Patient will be followed up in 3-months.Aug 14, 2013
|
|

Nearly complete coloboma1148 viewsNearly complete coloboma from necropsy of infant born with multiple congenital anomalies, incompatable with life, including holorprosencephaly. Infant expired on 3rd post-partum dayJul 18, 2013
|
|

50 Year Old woman with Congenital Retinal Vascular Tortuosity - Normal Vision924 viewsApr 08, 2013
|
|

50 Year Old woman with Congenital Retinal Vascular Tortuosity - Normal Vision978 viewsApr 08, 2013
|
|

50 Year Old woman with Congenital Retinal Vascular Tortuosity - Normal Vision1056 viewsApr 08, 2013
|
|

50 Year Old woman with Congenital Retinal Vascular Tortuosity - Normal Vision1177 viewsApr 08, 2013
|
|

Coates' Disease479 views38-year old male presents with decreased vision in the left eye. VA was 20/20-right eye and 20/70-left eye with pinhole no improvement. Fundus exam shows exudates near the macula and also exudates with small hemorrhages, superior nasally in the left eye. Mar 28, 2013
|
|

368 views38-year old male presents with decreased vision in the left eye. VA was 20/20-right eye and 20/70-left eye with pinhole no improvement. Fundus exam shows exudates near the macula and also exudates with small hemorrhages, superior nasally in the left eye. Mar 28, 2013
|
|

349 views38-year old male presents with decreased vision in the left eye. VA was 20/20-right eye and 20/70-left eye with pinhole no improvement. Fundus exam shows exudates near the macula and also exudates with small hemorrhages, superior nasally in the left eye. Mar 28, 2013
|
|

447 views38-year old male presents with decreased vision in the left eye. VA was 20/20-right eye and 20/70-left eye with pinhole no improvement. Fundus exam shows exudates near the macula and also exudates with small hemorrhages, superior nasally in the left eye. Mar 28, 2013
|
|

355 views38-year old male presents with decreased vision in the left eye. VA was 20/20-right eye and 20/70-left eye with pinhole no improvement. Fundus exam shows exudates near the macula and also exudates with small hemorrhages, superior nasally in the left eye. Mar 28, 2013
|
|

324 views38-year old male presents with decreased vision in the left eye. VA was 20/20-right eye and 20/70-left eye with pinhole no improvement. Fundus exam shows exudates near the macula and also exudates with small hemorrhages, superior nasally in the left eye. Mar 28, 2013
|
|

353 views38-year old male presents with decreased vision in the left eye. VA was 20/20-right eye and 20/70-left eye with pinhole no improvement. Fundus exam shows exudates near the macula and also exudates with small hemorrhages, superior nasally in the left eye. Mar 28, 2013
|
|

413 views38-year old male presents with decreased vision in the left eye. VA was 20/20-right eye and 20/70-left eye with pinhole no improvement. Fundus exam shows exudates near the macula and also exudates with small hemorrhages, superior nasally in the left eye. Mar 28, 2013
|
|

378 views38-year old male presents with decreased vision in the left eye. VA was 20/20-right eye and 20/70-left eye with pinhole no improvement. Fundus exam shows exudates near the macula and also exudates with small hemorrhages, superior nasally in the left eye. Mar 28, 2013
|
|

393 views38-year old male presents with decreased vision in the left eye. VA was 20/20-right eye and 20/70-left eye with pinhole no improvement. Fundus exam shows exudates near the macula and also exudates with small hemorrhages, superior nasally in the left eye. Mar 28, 2013
|
|

484 views38-year old male presents with decreased vision in the left eye. VA was 20/20-right eye and 20/70-left eye with pinhole no improvement. Fundus exam shows exudates near the macula and also exudates with small hemorrhages, superior nasally in the left eye. Mar 28, 2013
|
|

390 views38-year old male presents with decreased vision in the left eye. VA was 20/20-right eye and 20/70-left eye with pinhole no improvement. Fundus exam shows exudates near the macula and also exudates with small hemorrhages, superior nasally in the left eye. Mar 28, 2013
|
|

428 views38-year old male presents with decreased vision in the left eye. VA was 20/20-right eye and 20/70-left eye with pinhole no improvement. Fundus exam shows exudates near the macula and also exudates with small hemorrhages, superior nasally in the left eye. Mar 28, 2013
|
|

577 views38-year old male presents with decreased vision in the left eye. VA was 20/20-right eye and 20/70-left eye with pinhole no improvement. Fundus exam shows exudates near the macula and also exudates with small hemorrhages, superior nasally in the left eye. Mar 28, 2013
|
|

Congenital Hypertrophy of the Retinal Pigment Epithelium CHRPE has Satellite Lesions990 viewsMar 20, 2013
|
|

Congenital Hypertrophy of the Retinal Pigment Epithelium CHRPE has Satellite Lesions755 viewsMar 20, 2013
|
|

Congenital Hypertrophy of the Retinal Pigment Epithelium CHRPE has Satellite Lesions620 viewsMar 20, 2013
|
|

Congenital Hypertrophy of the Retinal Pigment Epithelium CHRPE has Satellite Lesions999 viewsMar 20, 2013
|
|

OD Albinism with foveal hypoplasia2202 views28 year old female latina with vision of 20/400Mar 05, 2013
|
|

FEVR FA Transit581 viewsFEVR in OS of a 14 yr old girlJan 11, 2013
|
|

578 viewsFEVR in OS of a 14 yr old girlJan 11, 2013
|
|

Retinal Coloboma1289 views14-year old male presents with decreased vision in the left eye. Dx with iris and retinal coloboma in the left eye. Patient VA was 20/20, right eye, 20/100 left eye with pinhole improvement 20\50. Patient was fitted for SCL in the left eye.Aug 16, 2012
|
|

Multifocal CHRPE also called "Bear Tracks"1005 viewsJul 09, 2012
|
|

Chorioretinal Scar1574 views21 year old male with a chorioretinal scar ODJun 21, 2012
|
|

CAVERNOUS HEMONGIOMA2119 views28 year old male. FAApr 20, 2012
|
|

CAVERNOUS HEMONGIOMA2744 views28 year old male w/ 20/200 vision at time of exam. Patient c/o poor vision since childhood. No significant medical history or family medical history. A problem was only noted when patient enlisted in the Army.Apr 20, 2012
|
|

Combined hamartoma of the retina and RPE2722 views16 year old female, diagnosed with a combined hamartoma of the retina and the retinal pigment epithelium.Apr 20, 2012
|
|

Wyburn-Mason Syndrome 1963 views28 year old female, diagnosed with Wyburn-Mason Syndrome at age 7. At time of exam, vision in the left eye was 4/200.Apr 20, 2012
|
|

Coats' Disease in 14 Year Old Boy Treated with Cryotherapy and Avastin684 views14 Year Old Boy with Coats DiseaseFeb 25, 2012
|
|

Coats' Disease in 14 Year Old Boy Treated with Cryotherapy and Avastin765 views14 Year Old Boy with Coats DiseaseFeb 25, 2012
|
|

Coats' Disease in 14 Year Old Boy Treated with Cryotherapy and Avastin796 views14 Year Old Boy with Coats DiseaseFeb 25, 2012
|
|

Coats' Disease in 14 Year Old Boy Treated with Cryotherapy and Avastin585 views14 Year Old Boy with Coats DiseaseFeb 19, 2012
|
|

Coats' Disease in 14 Year Old Boy Treated with Cryotherapy and Avastin643 views14 Year Old Boy with Coats DiseaseFeb 19, 2012
|
|

Coats' Disease in 14 Year Old Boy Treated with Cryotherapy and Avastin1773 views14 Year Old Boy with Coats DiseaseFeb 19, 2012
|
|

Coats' Disease in 14 Year Old Boy Treated with Cryotherapy and Avastin653 views14 Year Old Boy with Coats DiseaseFeb 19, 2012
|
|
Coats' Disease in 14 Year Old Boy Treated with Cryotherapy and Avastin827 views14 Year Old Boy with Coats DiseaseFeb 19, 2012
|
|

Myelinated Nerve Fiber Layer790 views69-year-old woman OD is 20/30, OS is 20/40. Feb 07, 2012
|
|

Myelinated Nerve Fiber Layer599 views69-year-old woman OD is 20/30, OS is 20/40. Feb 07, 2012
|
|

Myelinated Nerve Fiber Layer1091 views69-year-old woman OD is 20/30, OS is 20/40. Feb 07, 2012
|
|

Myelinated Nerve Fiber Layer782 views69-year-old woman OD is 20/30, OS is 20/40. Feb 07, 2012
|
|

Myelinated Nerve Fiber Layer688 views69-year-old woman OD is 20/30, OS is 20/40. Feb 07, 2012
|
|

wyburn-mason syndrome fundus photos1154 views28 year old female, visual acuity 20/200Jan 10, 2012
|
|

Wyburn Mason Syndrome3675 views28 year old female, visual acuity OS 20/200Jan 10, 2012
|
|

wyburn-mason sydrome1299 views28 year old female, visual acuity OS 20/200Jan 10, 2012
|
|

775 viewsPHPV - Left eye macular area. The patient was diagnosed as having regressed ROP even with a history of full term birth with no antecedent perinatal history of diseaseNov 17, 2011
|
|

1035 viewsPHPV - Left eye - optic nerveNov 17, 2011
|
|

932 viewsPHPV - right eye. Peripheral extension Nov 17, 2011
|
|

1641 viewsPHPV - right eye - optic nerveNov 17, 2011
|
|

Anomalous Branch Retinal Artery 972 views59-year-old man OD 20/25, OS 20/25. TORTUOUS RETINAL ARTERY – LEF EYE
(POSSIBLE GROUP 2 WYBURN-MASON SYNDROME
POSSIBLE ACEPHALIC MIGRAINES )Sep 02, 2011
|
|

Anomalous Branch Retinal Artery 654 views59-year-old man OD 20/25, OS 20/25. TORTUOUS RETINAL ARTERY – LEF EYE
(POSSIBLE GROUP 2 WYBURN-MASON SYNDROME
POSSIBLE ACEPHALIC MIGRAINES )Sep 02, 2011
|
|

Anomalous Branch Retinal Artery 856 views59-year-old man OD 20/25, OS 20/25. TORTUOUS RETINAL ARTERY – LEF EYE
(POSSIBLE GROUP 2 WYBURN-MASON SYNDROME
POSSIBLE ACEPHALIC MIGRAINES )Sep 02, 2011
|
|

Anomalous Branch Retinal Artery 659 views59-year-old man OD 20/25, OS 20/25. TORTUOUS RETINAL ARTERY – LEF EYE
(POSSIBLE GROUP 2 WYBURN-MASON SYNDROME
POSSIBLE ACEPHALIC MIGRAINES )Sep 02, 2011
|
|

Anomalous Branch Retinal Artery 998 views59-year-old man OD 20/25, OS 20/25. TORTUOUS RETINAL ARTERY – LEF EYE
(POSSIBLE GROUP 2 WYBURN-MASON SYNDROME
POSSIBLE ACEPHALIC MIGRAINES )Sep 02, 2011
|
|

Anomalous Branch Retinal Artery 778 views59-year-old man OD 20/25, OS 20/25. TORTUOUS RETINAL ARTERY – LEF EYE
(POSSIBLE GROUP 2 WYBURN-MASON SYNDROME
POSSIBLE ACEPHALIC MIGRAINES )Sep 02, 2011
|
|

Anomalous Branch Retinal Artery 684 views59-year-old man OD 20/25, OS 20/25. TORTUOUS RETINAL ARTERY – LEF EYE
(POSSIBLE GROUP 2 WYBURN-MASON SYNDROME
POSSIBLE ACEPHALIC MIGRAINES )Sep 02, 2011
|
|

Amelanotic - Light Colored CHRPE - Congenital Hypertrophy of the Pigment Epithelium5020 views56-year-old woman nov vision problems. OD is 20/20, OS is 20/16Sep 02, 2011
|
|

Amelanotic - Light Colored CHRPE - Congenital Hypertrophy of the Pigment Epithelium2695 views56-year-old woman nov vision problems. OD is 20/20, OS is 20/16Sep 02, 2011
|
|

CHRPE - Congenital Hypertrophy of the Pigment Epithelium - Peripheral1041 views55-year-old woman OD 20/30, OS 20/25Jul 24, 2011
|
|

CHRPE - Congenital Hypertrophy of the Pigment Epithelium - Peripheral1247 views55-year-old woman OD 20/30, OS 20/25Jul 24, 2011
|
|

Nanopthalmous (Microphthalmous) Chorioretinal Folds and Choroidal Thickening Both Eyes B-Scan Ultrasound938 viewsJun 28, 2011
|
|

Nanopthalmous (Microphthalmous) Chorioretinal Folds and Choroidal Thickening Both Eyes B-Scan Ultrasound937 viewsJun 28, 2011
|
|
|
|